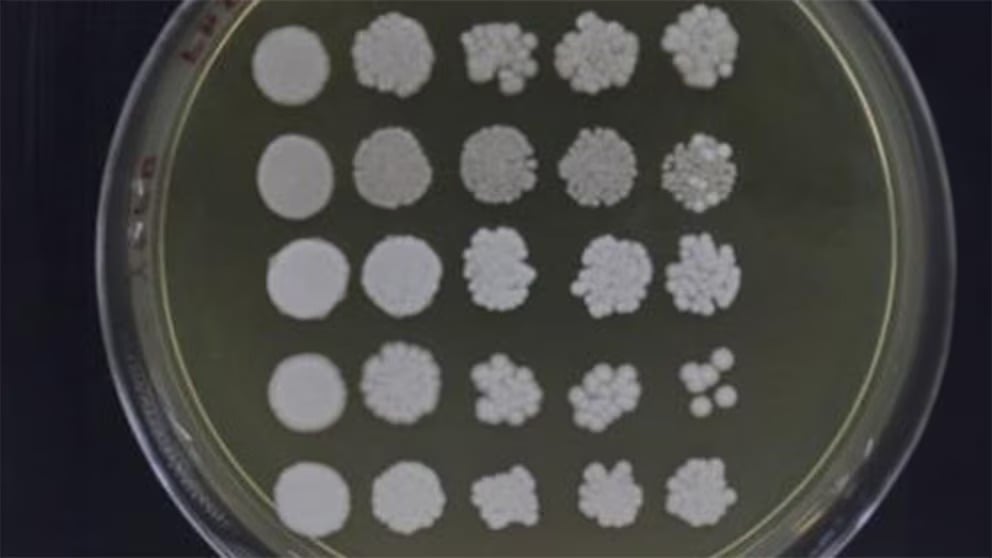

Alertan por candida parapsilosis, el hongo superresistente de fácil propagación en en hospitales de Argentina
 Es un patógeno de alta prioridad en la lista de la OMS. Por qué preocupa su presencia en hospitales del AMBA en Argentina
Es un patógeno de alta prioridad en la lista de la OMS. Por qué preocupa su presencia en hospitales del AMBA en Argentina Es un patógeno de alta prioridad en la lista de la OMS. Por qué preocupa su presencia en hospitales del AMBA en Argentina
Es un patógeno de alta prioridad en la lista de la OMS. Por qué preocupa su presencia en hospitales del AMBA en Argentina